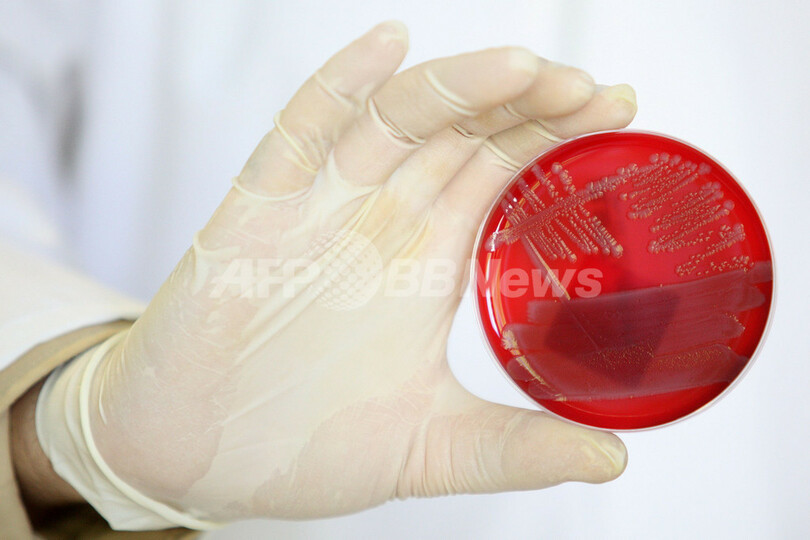
欧州で感染拡大の大腸菌O104、新種か

欧州で感染拡大の大腸菌O104、新種か
このニュースをシェア
【6月3日 AFP】ドイツを中心に欧州で18人の死者を出している腸管出血性大腸菌O104感染で、世界保健機関(WHO)は2日、ドイツ国内で確認された菌について「これまで感染拡大の例がない型」だと警告した。
一方、感染者が多く収容されているドイツ北部のハンブルク・エッペンドルフ大学病院(University Clinic Hamburg-Eppendorf)と提携する中国の北京ゲノム研究所(BGI)は同日、問題となっている病原菌のDNAを解析したところ、「全く新種の強毒性の菌」で、抗生物質に耐性を持つことが分かったと発表した。
また、米カリフォルニア(California)州の製薬会社ライフテクノロジーズ(Life Technologies)も、独自に検査を行った結果、病原菌が「新種の交配株」の可能性が示されたことを明らかにした。同社によると、問題の菌は腸管凝集性大腸菌(EAEC)と腸管出血性大腸菌(EHEC)が結合したもので、これが死者を出すほどの猛毒性の一因とみられるという。(c)AFP
一方、感染者が多く収容されているドイツ北部のハンブルク・エッペンドルフ大学病院(University Clinic Hamburg-Eppendorf)と提携する中国の北京ゲノム研究所(BGI)は同日、問題となっている病原菌のDNAを解析したところ、「全く新種の強毒性の菌」で、抗生物質に耐性を持つことが分かったと発表した。
また、米カリフォルニア(California)州の製薬会社ライフテクノロジーズ(Life Technologies)も、独自に検査を行った結果、病原菌が「新種の交配株」の可能性が示されたことを明らかにした。同社によると、問題の菌は腸管凝集性大腸菌(EAEC)と腸管出血性大腸菌(EHEC)が結合したもので、これが死者を出すほどの猛毒性の一因とみられるという。(c)AFP





